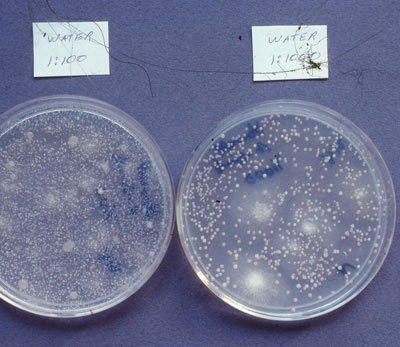
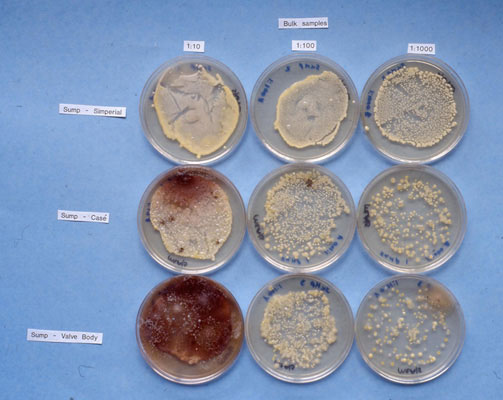
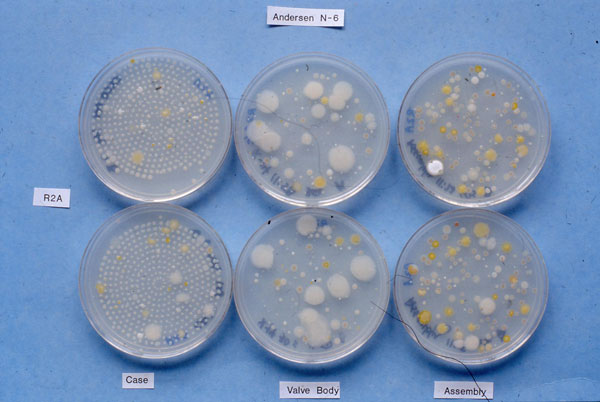
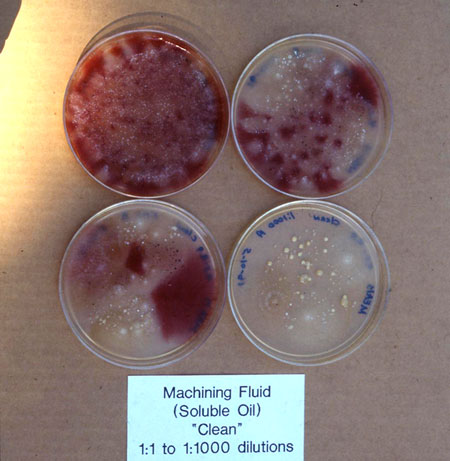

Hello hello,
I hope you had a nice summer and are enjoying the fall. What follows is an article about Machining Coolants by Dr. Harriet Burge and about the fungi Hygrocybe by Karen Santo-Pietro. I hope you'll find them interesting and helpful.
With best wishes,
Dave Gallup
Machining Coolants
By Dr. Harriet Burge
What Are They?
Machining coolants (also called cutting fluids, machining fluids, cutting oils, etc.) are liquids that are circulated over surfaces that are being ground or polished. They are used as lubricants, to cool surfaces, and to wash away the fine particles. Originally, these coolants were straight oils (mineral oil). This type of coolant remains in use, especially in small operations. Water-based coolants came into common use in the early twentieth century, and the majority of coolants in use today are water-based. The key word for us, of course, is water. If you add water to almost anything, you get microbial growth. The same is true of water-based machining coolants.
Water-based coolants can be grouped as synthetic, semisynthetic, and soluble. Synthetic coolants have no oil and are made from detergents, synthetic lubricants, and water. Semisynthetic coolants have small amounts of oil combined with detergents, synthetic lubricants, and water. Soluble coolants are oil/water emulsions. Once the coolant is in the system, it gradually accumulates contaminants that provide additional nutrients for microbes. These include cigarettes, food, and even spit and urine introduced into the system by workers. Animal droppings can also contaminate fluid in poorly maintained plants. All of these substances add microbes as well as nutrients. In one case that I investigated, pigeon droppings may have been responsible for the introduction of Mycobacterium into a fluid system.
Figure 1: Dilution culture of the water used to make up the coolant.
Copyright © 2006 Environmental Microbiology Laboratory, Inc.
Microbial Populations in Coolants
All of these water-containing coolants will support microbial growth, but no data are available that indicate differences in population structure among the different types. In fact, most available data has been collected using cultural methods, which not only drastically underestimate concentrations, but also yield an abundance of unknown organisms. Based on these limited data, we can say a few things about MWF microbial populations. Generally, metalworking fluid (MWF) bacterial populations are dominated by Gram negative organisms with species of Pseudomonas especially abundant. However, populations change over time. Early invaders (at least in some fluids) are species of Klebsiella and other organisms that can survive in very dilute solutions. As nutrients accumulate in the fluid and rich biofilms develop, populations increase and change in structure. As fluids age, populations become dominated by a few species and remain relatively stable.
In some coolants, for unknown reasons, Gram positive organisms will become established. These organisms (Mycobacterium species) colonize the mature biofilm, and multiply in the fluid under unknown conditions. Mycobacterium in fluid and associated outbreaks of disease are apparently recent phenomena. Some theories for their invasion include changes in fluid formulations so that the environment favors growth of these organisms, or the excessive use of biocides to which the mycobacteria are resistant. The presence of this is an urgent area of research in view of the well-documented health effects of these organisms (see below). Finally, fungi can also colonize the fluids. The most common fungi isolated are species of Fusarium and Acremonium, although others may also be present. The fungi are usually present in much lower concentrations than the bacteria, and their presence indicates that the fluid is out of control.
Figure 2: Dilution culture of coolant, documenting the massive bacterial concentrations.
Dilutions are reversed (most concentrated on the left). The red color is due to fungi (fusarium). Note how it only shows up on the most concentrated dilution. It is present in low concentrations, but produces biocides that allow it to overcome the bacterial growth.
Copyright © 2006 Environmental Microbiology Laboratory, Inc.
Documented Health Effects
Cancer
One of the reasons for the switch from mineral oil to water based coolants was evidence that inhaling the oil coolants caused cancer. Cancer has not been reported in association with water-based coolants.
Dermatitis
Straight oil coolants were notorious for causing dermatitis. With water-based coolants, the presence of fungi appears to be associated with outbreaks of dermatitis, although single cases occur for other reasons in susceptible people.
Respiratory Irritation and Asthma
Because of the abundance of Gram negative organisms and thus endotoxin, respiratory irritation does occur in poorly maintained fluids, although epidemiologically, the effects are small. Work-related asthma has also been reported, although the actual agents in the coolants that lead to asthma are unknown.
Hypersensitivity Pneumonitis
A number of epidemics of hypersensitivity pneumonitis have occurred in connection with MWF exposure. In most of these cases, Mycobacterium species have been recovered from the fluid.
Figure 3: A group of duplicate air samples from three sites.
The left-most plates are controls where little or no coolant was present. These are common human skin surface bacteria. Note the very high levels of airborne Gram negatives (in this case) on the right set.
Copyright © 2006 Environmental Microbiology Laboratory, Inc.
Approaches for Control
Exposure Control
Especially in view of the many unknowns associated with machining coolant microbial populations, the best approach to control of MWF associated disease is exposure control. Local exhaust ventilation is effective at preventing most exposure. Unfortunately, many machining plants are old and retooling to provide this kind of ventilation is expensive. Personal protective equipment could be used (filter masks); however, there would always be a problem with compliance. This approach could be useful in workers who have developed asthma or hypersensitivity pneumonitis, providing they wish to continue to work as machinists. Especially with hypersensitivity pneumonitis, exposure control is crucial to prevent chronic or even fatal lung disease. Changing formulations to reduce mist formation as been another approach, but is not sufficient on its own.
Controlling Composition of the Fluids
It would be nice to be able to either prevent microbial growth, or to keep the growth under sufficient control so that exposure would not represent a hazard. Unfortunately, we don't know how to do this. Fluid is monitored principally for concentrations of bacteria using dipstick methods. Biocides are added when concentrations are too high, or when the pH falls due to microbial activity. These measures were instituted to protect the fluid since the microbes actually digest the fluids and render them ineffective as lubricants.
Figure 4: "Clean" soluble oil at dilutions 1:1-1:1000.
It is relatively obvious which dilutions are which (upper right 1:1, lower left 1:1000. Note the fungi in this "clean" fluid.
Copyright © 2006 Environmental Microbiology Laboratory, Inc.
Investigations in the Machining Coolant Environment
Investigations are usually conducted to allow the designing of remediation protocols. Once can certainly look for "cleanliness" of the plant, and quality of the fluid. Microbiologically, one can look for fungi, and for Mycobacterium, neither of which should be present. Short of some well-designed research that leads to answers with respect to the factors that control microbial growth in MWF, sampling data are nearly impossible to interpret except for the presence of mycobacteria and fungi. Ideally, those of us interested in microbial contamination of indoor environments should collaborate to develop a data base that would eventually lead to predictive models for the progression of microbial changes in MWF.
Useful Websites:
1. Metalworking Fluids - Safety and Health Best Practices Manual
2. NIOSH - Metalworking Fluids
3. E1497-05 Standard Practice for Safe Use of Water-Miscible Metal Removal Fluids
4. Extending the Life of Metal Working Fluids
Microorganism of the Month: Hygrocybe species (waxcaps)
By Karen Santo-Pietro
Hygrocybe species are mushrooms with very distinct morphology. They have delicate, hollow stalks and slimy pilei (caps) that grow up to about 2" in diameter. Their bright coloration makes them highly visible. For example, Hygrocybe conica (Figure 1) exhibits an orange conical shaped cap that blackens with time. It occurs around Halloween in coniferous and mixed conifer/hardwood woodlands, thereby, deriving its common name: the witches' hat or blackening mushroom. H. psittacina (Fig. 2) is called the parrot mushroom because of its changing color from green to yellow as it ages. H. miniata (Fig. 3) is bright vermilion and easy to identify.

Figure 1: Hygrocybe conica (witches' hat or blackening mushroom).
Photo courtesy of Dr. George Barron, MycoAlbum CD.
Hygrocybe spp. belong to the family Hygrophoraceae. Members of this family are characterized by the presence of a waxy substance on the gills. Consequently, they are commonly called waxcap or waxy cap fungi. Hygrophoraceae also exhibit basidiospores that are colorless and have thin, smooth walls. The spores also appear to contain large, refractive oil guttules (oil droplets). The spores have little or no tendency to collapse after dispersal.
Within the Hygrophoraceae family, Hygrocybe spp. was formerly lumped under the genus Hygrophorus but later placed under a separate new genus because of morphological differences. On a macroscopic level, Hygrocybe spp. are smaller and usually have brighter colors than Hygrophorus spp. On a microscopic level, the most important distinguishing characteristic is gill trama morphology. Gill trama is composed of hyphae under the layer of basidia (basidiospore-bearing structures) and basidiospores. Hygrocybe spp. exhibit a parallel to subparallel arrangement of gill trama hyphae while Hygrophorus spp. have a divergent orientation.

Figure 2: Hygrocybe psittacina (parrot mushroom).
Photo courtesy of Dr. George Barron, MycoAlbum CD.
The basidia (basidiospore-bearing structures) of the Hygrocybe spp. are borne on the outside of the gills. The basidiospores also exhibit a unique characteristic: a very large node-like hilar scar on the hilar appendix. A few species are characterized by an obvious median constriction on the basidiospore. A few species, such as Hygrocybe firma, produce basidia that bear 2 spores (bisporic) or 4 spores (tetrasporic). Consequently, H. firma basidiospores have two size ranges, 9.7-14 x 5.2-8µm and 5.5-8.5 x 4-5.3µm, depending on which basidia they arise from.
In Northern and Western Europe, many species of Hygrocybe are commonly found in grassland ecosystems. A few species, such as H. viola and H. quieta, are usually found in woodlands. In North America, they are more often found in woodland ecosystems. They are oftentimes associated with moss and are also believed to have a mycorrhizal association with hardwoods and conifers. They are common under oak, pine, fir and redwoods. Many species are found in California.

Figure 3: Hygrocybe miniata (vermilion mushroom).
Photo courtesy of Dr. George Barron, MycoAlbum CD.
Hygrocybe spp. are best observed in the fall, when diversity and numbers are at their peak. Millions of basidiospores per hour are released into the air during this season. Although there is no clear evidence, the high spore count may cause allergic reactions in sensitive individuals that hike or live in the area. Investigating this correlation would be an interesting topic for future study.
Hygrocybe spp., if eaten, tends to be bland and watery. They are not poisonous but a few may cause sickness. Photographing these mushrooms would be a safer and more interesting option than eating them. If you plan to go mushroom hunting, now would be the perfect time. So bring a guide book and camera, and head out for a conifer forest near you.
References:
1. Arora, D. 1979. Mushrooms demystified. A comprehensive guide to the fleshy fungi of the central California coast. Ten Speed Press, Berkeley, CA. Pp. 94-96.
2. Barron, G. 2006. MycoAlbum CD for Introductory Mycology. MycoGraphics, Guelph, Ontario, Canada.
3. Hygrocybe Conica: The Witch's Hat Mushroom
4. Hygrocybe Genus
5. What are Waxcaps?
6. Pegler, D.N. and Young, T.W.K. 1971. Basidiospore Morphology in the Agaricales. Verlag Von J. Cramer, Lehre, Germany. Pp. 25, 28-29.